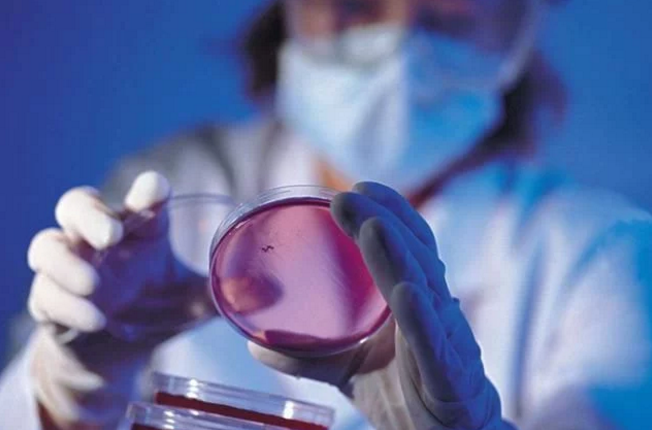
微信截图_20180108154739

如果一辆汽车是用亚麻和甜菜制造的,你敢开吗?
荷兰埃因霍温理工大学生物汽车团队今年就造了这么一款“绿色纯天然”的汽车,除了车轮和悬架系统,其他部分均使用由亚麻和甜菜制成的生物基复合材料,大特点是可实现生物降解和轻量化。
相比传统汽车的用料,生物基材料相对更轻。现在有很多企业选择使用铝和碳纤维材料代替钢材来生产更加轻量化的汽车,但是,在加工上所耗费的能量成倍增加。因此,生物基材料便剑走偏锋,成为汽车轻量化的个性选择。

可以说,这款“绿色纯天然”的汽车是科研界对汽车轻量化探索的成形“脑洞”,值得鼓励。但同时,对生物基材料汽车安全性、耐久性、经济性和工艺性等基础问题的探索也不应停止,它们决定着亚麻和甜菜终能否成为一辆真正的汽车。

English
简体中文